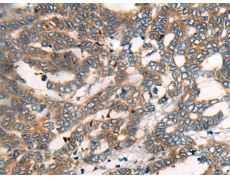
一抗

Background:
Substrate-specific adapter of a DCX (DDB1-CUL4-X-box) E3 ubiquitin-protein ligase complex required for cell cycle control, DNA damage response and translesion DNA synthesis. The DCX(DTL) complex, also named CRL4(CDT2) complex, mediates the polyubiquitination and subsequent degradation of CDT1, CDKN1A/p21(CIP1), FBXO18/FBH1 and KMT5A (PubMed:16861906, PubMed:16949367, PubMed:16964240, PubMed:17085480, PubMed:18703516, PubMed:18794347, PubMed:18794348, PubMed:19332548, PubMed:20129063, PubMed:23478441, PubMed:23478445, PubMed:23677613). CDT1 degradation in response to DNA damage is necessary to ensure proper cell cycle regulation of DNA replication (PubMed:16861906, PubMed:16949367, PubMed:17085480). CDKN1A/p21(CIP1) degradation during S phase or following UV irradiation is essential to control replication licensing (PubMed:18794348, PubMed:19332548). KMT5A degradation is also important for a proper regulation of mechanisms such as TGF-beta signaling, cell cycle progression, DNA repair and cell migration (PubMed:23478445). Most substrates require their interaction with PCNA for their polyubiquitination: substrates interact with PCNA via their PIP-box, and those containing the 'K+4' motif in the PIP box, recruit the DCX(DTL) complex, leading to their degradation. In undamaged proliferating cells, the DCX(DTL) complex also promotes the 'Lys-164' monoubiquitination of PCNA, thereby being involved in PCNA-dependent translesion DNA synthesis (PubMed:20129063, PubMed:23478441, PubMed:23478445, PubMed:23677613).
Applications:
ELISA, IHC
Name of antibody:
DTL
Immunogen:
Fusion protein of human DTL
Full name:
denticleless E3 ubiquitin protein ligase homolog
Synonyms:
CDT2; RAMP; DCAF2; L2DTL
SwissProt:
Q9NZJ0
ELISA Recommended dilution:
5000-10000
IHC positive control:
Human thyroid cancer and Human liver cancer
IHC Recommend dilution:
20-100


 購物車
購物車 幫助
幫助
 021-54845833/15800441009
021-54845833/15800441009